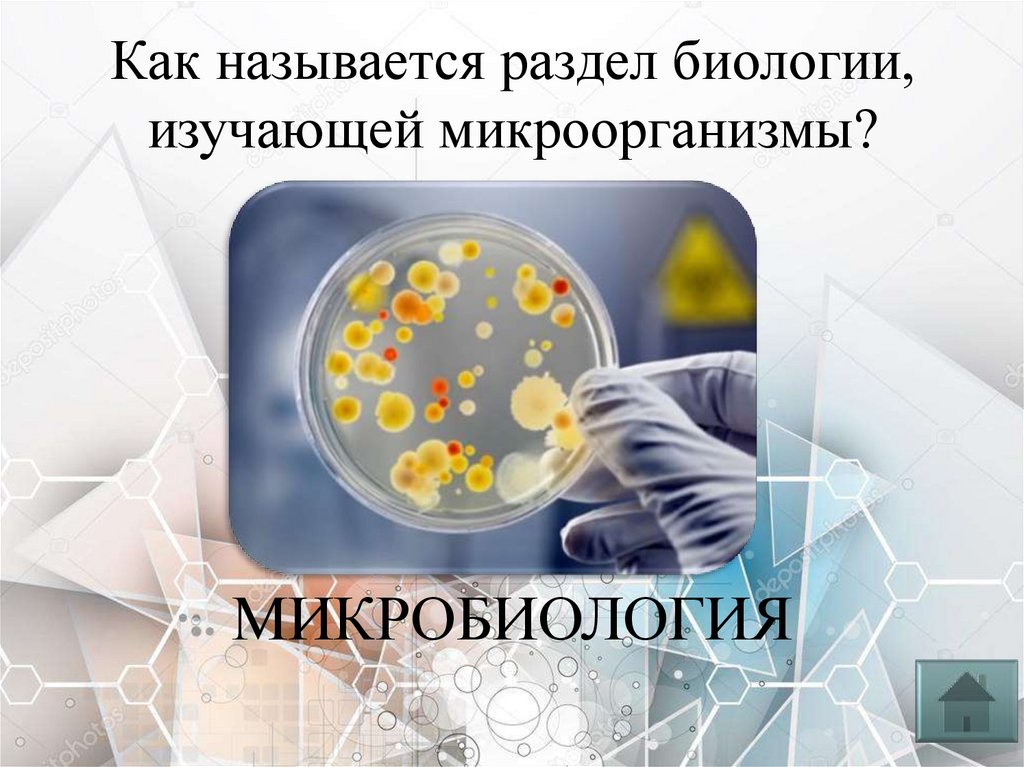

Similar presentations:
Своя игра «Таинственная биология» (5 класс)
1. Своя игра «Таинственная биология» познавательная биологическая игра (5 класс)
ПРАВИЛА ИГРЫ2.
ЦарствоБактерии
Науки
Царство
Грибы
Биология
Царство
Царство
одним
Растения Животные
словом
1
2
3
0
0
0
3.
Без живого нельзя представить себенашу планету. А как называется наука о
живой природе?
?
БИОЛОГИЯ
4.
Эта наука изучает разнообразныерастения, а как называется наука о
растениях
БОТАНИКА
5.
На нашей планете обитаютразнообразные животные. Какая наука
изучает животных?
ЗООЛОГИЯ
6.
Как называется раздел биологии,изучающей микроорганизмы?
МИКРОБИОЛОГИЯ
7.
Назовите биологическую науку, котораяизучает строение и жизнедеятельность
клеток?
ЦИТОЛОГИЯ
8.
Бактерии по форме очень разнообразны.Одиночные бактерии округлой формы
называются?
КОККИ
9.
Как размножаются бактерии?ДЕЛЕНИЕМ КЛЕТКИ НАДВОЕ
10.
В пищевой промышленности дляполучения простокваши и сметаны
используются?
МОЛОЧНОКИСЛЫЕ БАКТЕРИИ
11.
Клетки бактерий являютсябезъядерными, поэтому их называют?
ПРОКАРИОТЫ
12.
Бактерии, имеющие извитую форму.ВИБРИОНЫ
13.
Грибы, получающие питание за счетдругих живых организмов?
ПАРАЗИТЫ
14.
Особые клетки, с помощью которыхгрибы размножаются?
СПОРЫ
15.
Второе название грибницы?МИЦЕЛИЙ
16.
Какие грибы используют для полученияантибиотиков?
ПЛЕСНЕВЫЕ ГРИБЫ
(ПЕНИЦЦИЛИН)
17.
Я в красной шапочке расту подстройною осиною, меня узнаешь за
версту, зовусь я ...?
ПОДОСИНОВИК
18.
Совокупность всех растений планеты,названных в честь древнегреческой
богини мифологии?
ФЛОРА
19.
Растения, у которых есть цветки иплоды?
ЦВЕТКОВЫЕ
20.
Растёт на влажных местах. Имеет стеблии листья, но у него не бывает корней,
цветков и плодов с семенами?
МХИ
21.
Образование органических веществ изуглекислого газа и воды, на свету, с
выделением кислорода. Что это за
процесс?
ФОТОСИНТЕЗ
22.
Как называется пигмент, придающийрастениям зеленый цвет?
ХЛОРОФИЛЛ
23.
Самые влюбленные птицы?ЛЕБЕДИ
24.
Какой тип животных имеют внутреннийскелет?
ТИП ХОРДОВЫЕ
25.
В Африке существуют соревнования поскачкам на этих огромных птицах.
Назовите их.
СТРАУСЫ
26.
Чем питаются животные?(какими веществами)
ГОТОВЫМИ ОРГАНИЧЕСКИМИ
ВЕЩЕСТВАМИ
27.
Какие классы животных относят к типучленистоногих?
КЛАСС РАКООБРАЗНЫЕ
КЛАСС ПАУКООБРАЗНЫЕ
КЛАСС НАСЕКОМЫЕ
28.
Какое слово объединяет следующиеприлагательные: лестничная, шахматная,
грудная, растительная, нервная,
мышечная, птичья, звериная…
КЛЕТКА
29.
Назовите одним словом: растения,грибы, животные и бактерии
ЦАРСТВА
30.
Назовите одним словом плесень,сыроежки, дрожжи.
ГРИБЫ
31.
Назовите одним словом ботаника,зоология, микология, микробиология,
анатомия и т.д.
НАУКИ
32.
Назовите одним словом кокки,вибрионы, спириллы, бациллы.
БАКТЕРИИ
33.
В игре принимают участие 3 команды.Участники игры выбирают номинацию и количество
балов, (участник определяется жребием).
Выбрав категорию и цену вопроса (определяющая
сложность вопроса) вы попадаете на слайд с заданием.
Время на обдумывание (20 секунд).
Если участник одной команды дал неправильный ответ,
то этот же вопрос переходит к следующей команде.
В конце игры подсчитывается общее количество баллов
у каждой команды и выбирается победитель.

biology
biology








